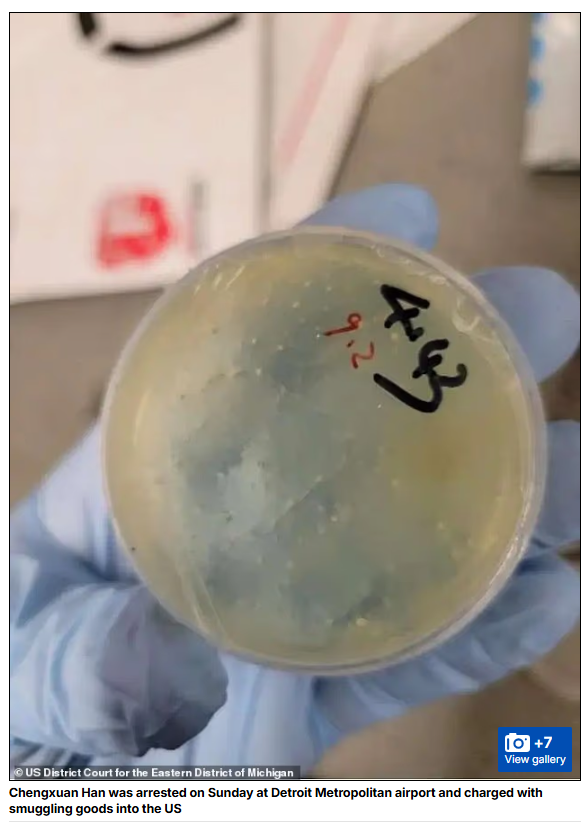

战斗在敌人心脏正义学者再次携生物病原体入美.天津大爆炸10年祭

2015年8月12日星期三 23时33分55秒
天津大爆炸10年了,真相都在这里! https://t.co/eU9yKwm8IJ pic.twitter.com/HPHEOoihEg
— 新闻调查 (@xinwendiaocha) June 10, 2025


https://veteranstoday.com/2021/07/07/confirmation-tianjin-was-nuked-in-2015/




Low end yields of very high efficiency can be easily created with no minimal critical mass problems to overcome.



可以轻松实现非常高效率的低端产量,
而没有最小的临界质量问题需要克服。


In the newest 5th generation devices the uranium or plutonium fissile content has been drastically reduced by as much as 90% only leaving enough fissile material needed to ignite and trigger the internal fission-fusion-fission reaction of the deuterium boost gas. In this process, almost all of the fissile material is totally consumed, producing almost no detectable traces of fallout, as compared to the older designs from the WW2 era.





这是天津大爆炸炸出的弹坑。从照片中看,这个弹坑的直径同图中的天津港公安局大楼的长度相当。就是说,天津大爆炸的一个弹坑的直径就有40米!










又有谁能找出一个类似灾难 是由意外事故引爆了民用的易燃易爆物资 能够造成方圆一公里内的汽车瞬间报废?




https://www.theinteldrop.org/2025/01/18/the-history-of-
nuclear-weapons-design-1945-2015-banned-by-national-

https://www.nbcnews.com/news/world/tianjin-explosions-
californian-witness-filmed-dramatic-china-blasts-n409701
正能量不装了 ————
👁?🔥在昨晚洛杉矶市中心的暴乱中,突然赶来的警察逮捕涉嫌抢劫者! https://t.co/oXldUAgLZi pic.twitter.com/87SAh2wo5q
— 淘喵先生 (@Baoliaogeming64) June 10, 2025
我的天哪🚨洛杉矶现在有数百人在抢劫阿迪达斯, 他们会把这怪到特朗普头上
— 诗和远方 (@RealColidora3) June 10, 2025
加州已经沦陷pic.twitter.com/9KhGtL3rvE
旧金山的革命群众也发动起来了
反ICE暴乱活动已蔓延至旧金山。
— 淘喵先生 (@Baoliaogeming64) June 11, 2025
毫不奇怪。 🤦?♂?🤦?♂? pic.twitter.com/71e1uiRppx
💥💥丹佛也开始了!
— 淘喵先生 (@Baoliaogeming64) June 11, 2025
反 ICE 暴徒占领了街道,警方已宣布丹佛的集会为非法集会
催泪弹已投放
这是针对美国的有组织的破坏稳定行动
资助这些活动的人必须立即被逮捕???? pic.twitter.com/OjYPQ23u4Q
🔥🔥反 ICE 暴徒现在正在冲击纽约警察局的路障,并很快被警察摔倒在地!
— 淘喵先生 (@Baoliaogeming64) June 11, 2025
美国各地的此类对抗正变得越来越激烈???? pic.twitter.com/1VJmtTVDax
🔥在一名反 ICE 暴徒进入下水道系统,并放置可疑物品后,
— 淘喵先生 (@Baoliaogeming64) June 11, 2025
??芝加哥警方目前正在向市中心部署 B0MB (拆弹小组)小队
这真是一片混乱💥
已经非常接近需要向芝加哥部署国民警卫队了! pic.twitter.com/EAfBZgD8Xy
组织负责派发面罩
🚨 满载仿生面罩的卡车出现在洛杉矶街头, 准备分发给暴徒。
— 诗和远方 (@RealColidora3) June 10, 2025
??“他们像发糖果一样分发!”
??每辆卡车都装载着价值数千美元的物资;
??看样他们有做长远抗争的计划!
??司法部必须查明并起诉资助此事的人员! pic.twitter.com/bc7BvFF0cz

🇺🇸🔥与此同时,在洛杉矶
— 淘喵先生 (@Baoliaogeming64) June 9, 2025
注意看,左翼激进暴徒披着什么
这是苏联共产党镰刀锤子旗
这是一场什么性质的暴乱
显然不言而喻???? pic.twitter.com/3NCiM92OLG
唐浩:洛杉磯暴動事件以及5月發生在華盛頓DC的反猶太人槍擊案,背後很可能都與一名富商和中共有關。 佛州眾議員Anna Luna引用調查資料指出,洛杉磯暴動背後涉及了兩個左翼組織PSL(Party for Socialism and Liberation (PSL))以及ANSWER(Act Now to Stop War and End Racism)。
而DC槍擊案的兇嫌Elias Rodriguez,曾經是ANSWER的成員。 這兩個組織的幕後金主,是71歲的富豪 Neville Roy Singham,Singham不但反猶太,還是個極左派社會主義者,更重要的是,他還是中共的「好朋友」。
2023年,紐約時報曾經披露Singham在幫助中共推動全球海外宣傳運動,為中共做大外宣,並陸續在海外成立許多類似PSL的左翼組織。
當時紐時的報導稱,「鮮為人知的是,Singham與中國的官方媒體密切合作,並以眾多非營利組織和空殼公司為掩護,為其在全球的宣傳活動提供資金。」 儘管中共極力隱藏 Singham的存在,但2023年7月一場復旦大學承辦的中共官方活動,照片卻意外曝光了Singham到場與會的身影(詳見圖4)。
因此,近期發生在美國的種種以「反猶太」為名的暴動與槍擊案,究竟是Singham的個人意志所推動?還是中共幕後指揮、通過Singham在海外推動與執行,從而達成製造美國內亂、顛覆美國政局的超限戰目的?值得追蹤

万维特派正能员 最听总领馆指挥!











